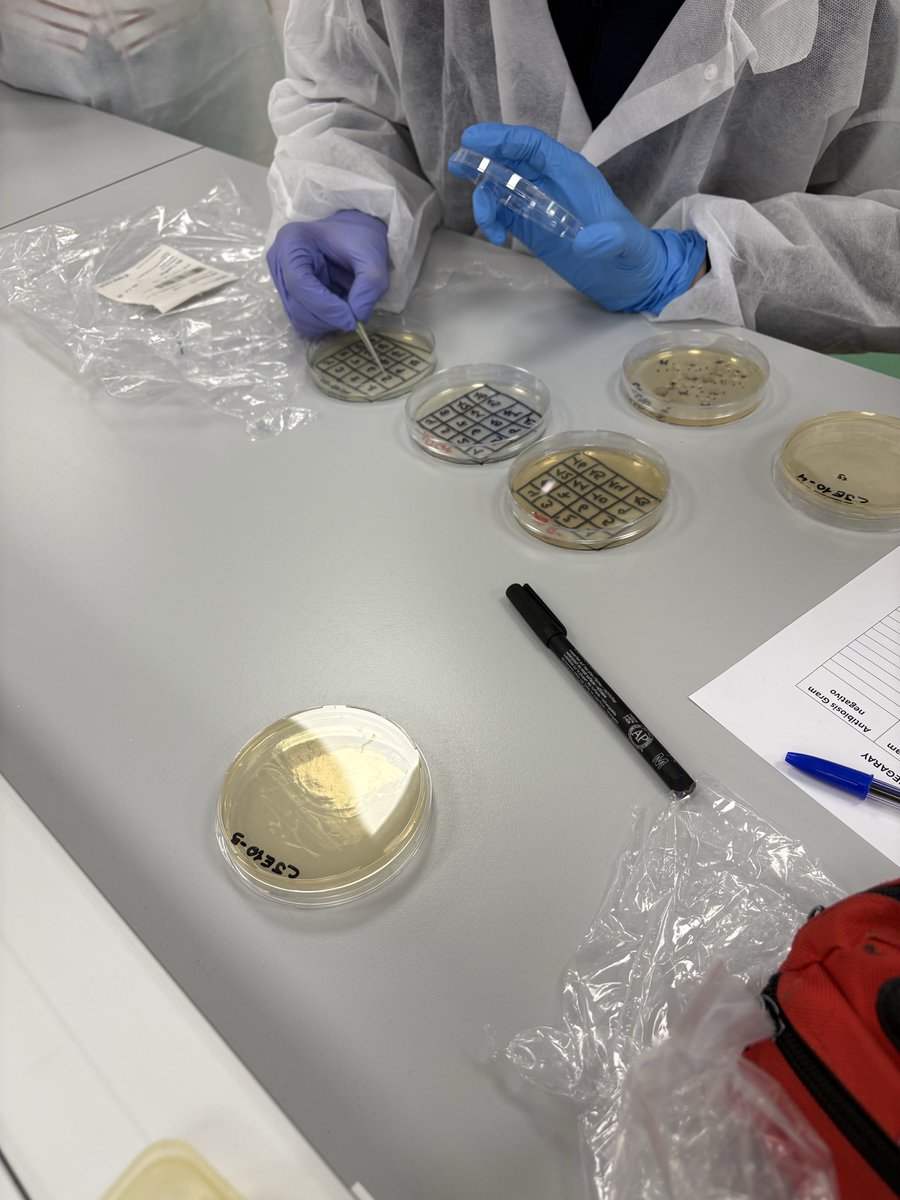
miridome8's tweet image. Tercer día de Micromundo en el CEIPSO José Echegaray @esmisionposible

#comun_ess search results
Aquest divendres tindrà lloc el #Comun_ESS, la III edició del congrés de #comunicació transformadora que impulsen plegades @XES_cat i @Reas_Red. ➕ info aquí 👉 ow.ly/gsGT30nVMtI @LaClaraComunica @diesdagost @LaTremendaCoop @laperacoop

Aquesta proposta és molt interessant! Gràcies #Comun_ESS Inscipcions obertes!
#Comun_ESS Ja tenim a punt el programa pel III congrés de #comunicació i economia solidària! Reflexionarem i aprendrem com construïr estratègies de difusió fora del model econòmi hegemònic. Vols sumar-t-'hi? Inscripcions obertes! xes.cat/2019/02/07/obr…

La Fundació @rocagales ja ha publicat #CooperacióCatalana 429 on hi apareixen➡️@assCandela @CarmeCherranz @FSMET_2020 #comun_ESS @CooperativesCAT @LaCoordiCat @carlaliebana @nusosSCCL @COS_Cooperativa @EspaiContraband @FoodCoopBCN @CegecopVNG 🖱 ow.ly/KGjv30o6wnQ

📚 #formacio | Demà i dissabte estarem al #Comun_ESS, la III edició del congrés de #comunicació transformadora, amb la @XES_cat i @Reas_Red. Moltes ganes! 🙌😊

En #Comun_ESS, aprendiendo de memes, #Marketing y aplicaciones mv para poder llegar a más gente. Objetivo: #Transición ecosocial allá vamosssssssss!

📚 #formacio | Genial taller amb l'@Apostrof_coop a #Comun_ESS! Debat sobre la imatge i l'estètica amb la que estem construint els nostres missatges. Molts reptes per davant! #crucrucru

Laia Tresserra, compa de @opcions, nos habla de #ConsumoConsciente y estrategias para fomentarlo en el carrusel de buenas prácticas de #Comun_ESS

A #Comun_ESS per reflexionar com comunicar sense renunciar als valors de l'economia social i solidària

En menys de dues hores comença a la @Lleialtat #Comun_ESS, una trobada organitzada per @XES_cat i @Reas_Red per construir un nou paradigma comunicatiu que incorpori i reprodueixi els valors de l’economia social i solidària. xarxanet.org/agenda/tercera…
¿Tienes una herramienta o clave comunicativa de éxito para la promoción de tus productos y servicios? En #Comun_Ess queremos conocerla para nuestro próximo encuentro. Más info y formulario de propuestas en: xes.cat/es/2019/01/08/…

Avui assistim al III Congrés de comunicació d’economia social i solidària #Comun_ESS organitzat per @XES_cat i @Reas_Red Anem a inspirar-nos per ajudar a comunicar millor.

Hoy intervenimos en el #carruseldebuenaspracticas del #Comun_ESS hablando de una forma más amable de comunicar y del proyecto de #iconosparaladiversidad con el que hemos querido #reventarestereotipos y que puedes descargar en waitala.com/iconos-diversi…

Felipe G. GIL @abrelatas nos sigue llevando por el camino del humor para petarlo por estas ondas y aprender también de experiencias desastrosas. Y lo estamos gozando, ritmo de remezcla, en #Comun_ESS

Contentas por participar en una nueva edición de #Comun_ESS Escuchando, hablando y aprendiendo cómo comunicar la economia social y solidaria 🙌 Gracias @XES_cat @Lleialtat @Reas_Red 😍

Quins són els reptes comunicatius de l'economia solidària? Amb quina imatge i estètica estem construint el nostre imaginari? Taller pràctic i debat col.lectiu amb l'@Apostrof_coop dins del cicle #crucrucru. #Comun_ESS



Què pot fer viral un contingut? 💫la mida i la profunditat 💫 que connecti amb les emocions 💫 la imatge i el copy 💫 l'humor, l'humor i l'humor! Com sortir de l'endogàmia By @DolorsBoatella a #Comun_ESS @XES_cat ➕ ow.ly/KpvE50rK2IG
Us compartim aquest article de @waitala_ on es resumeixen alguns dels reptes comunicatius de l'Economia Social que vam afrontar durant el #Comun_ESS i les seves conclusions <3 Gràcies! waitala.com/ca/5-conclusio… @XES_cat @Reas_Red @SomEnergia

Avui i demà el III Congrés de comunicació transformadora #Comun_ESS amb la relatoria col·laborativa amb @seguimfils i demà matí #CommonsCloud per cooperativitzar els núvols #FesElSalt teixidora.net/wiki/COMUNESS19 @XES_cat


Hoy comienza #Comun_ESS, el IV Congreso de Comunicación y Economía Social y Solidaria, para hacer piña🍍💚 Tres días de encuentro, aprendizajes y red. Muchas gracias @Reas_Red por hacerlo posible Más info: economiasolidaria.org/comuness-2022/
Fiestas de Alcorcón ✅ Adaptación de la guarde ❌ Plenario del curre ❌ #Comun_ESS ❌ #Septiembre
📣 Se acerca #COMUN_ESS: el IV Encuentro de Comunicación y #EconomíaSolidaria que se celebra del 28 al 30 de septiembre en Toledo📍 🗣 Contará, entre otras, con @ElSaltoDiario @lamarea_com y @pikaramagazine ℹ Toda la info.: economiasolidaria.org/comuness-2022
🚀 #EMESnetwork will join the Conference on Transformation in Communication in #SSE 📅 Toledo(Spain), 28-30 September 2022. @Reas_Red #COMUN_ESS 👇👇
🥁 Tachán-Tachán: Os presemos el retorno de #ComunESS, lo más puntero en #Comunicación y #EconomíaSolidaria. Abrimos HILO 👇 para presentaros lo que nos depara esta IV edición, que tendrá lugar en #Toledo del 28 al 30 de septiembre. #ComunESS2022 allá vamos...🚀

💭¿Quieres aumentar la visibilidad de tu organización en medios? 🙌No te pierdas #COMUN_ESS: el IV Encuentro de Comunicación y Economía Solidaria que contará con medios cooperativos como @ElSaltoDiario @lamarea_com y @pikaramagazine. 👉Más info: economiasolidaria.org/comuness-2022

Pintaza, que la #EconomíaSolidaria será #Feminista o no será! No se la pierdan gentes de #Comun_ESS Gracias, compas de @REASEuskadi y @pikaramagazine por el curro.💚💜
Nueva publi de @REASEuskadi con la colaboración de @pikaramagazine , recién salidita del horno! Claves prácticas para poner en marcha formas de comunicación con perspectiva de género :: checklist labur.eus/e4ugk

Cada cop més cooperatives que fan formació són presents a la plataforma @Educoop_ESS #ProjecteLaCo impulsat per @Trama_cultura. Ja són més de 50. Ara @Apostrof_coop ens hi comparteix material elaborat a partir de #Comun_ESS
🦾Estem d'estrena! Ja tenim perfil a @Educoop_ESS, la plataforma educativa que aglutina el conxeixement cooperatiu. Comencem amb un material de reflexió sobre comunicació i ESS a partir d'una de les trobades de #Comun_ESS. Aviat, més novetats! 💫 bit.ly/2Td75iv

12 impressões sobre comunicação e economia solidária, pela @Apostrof_coop labcoop.coop/wp-content/upl… #comun_ess
🦾Estem d'estrena! Ja tenim perfil a @Educoop_ESS, la plataforma educativa que aglutina el conxeixement cooperatiu. Comencem amb un material de reflexió sobre comunicació i ESS a partir d'una de les trobades de #Comun_ESS. Aviat, més novetats! 💫 bit.ly/2Td75iv

🦾Estem d'estrena! Ja tenim perfil a @Educoop_ESS, la plataforma educativa que aglutina el conxeixement cooperatiu. Comencem amb un material de reflexió sobre comunicació i ESS a partir d'una de les trobades de #Comun_ESS. Aviat, més novetats! 💫 bit.ly/2Td75iv

📢 Ara que ve la #FESC2019 recuperem aquesta presentació sobre Com sortir de l'endogàmia comunicativa que va compartir @DolorsBoatella a #Comun_ESS 👀 ow.ly/KpvE50rK2IG @XES_cat @LaClaraComunica @crearsa @colectic_coop
#Trabajo y #Consumo son dos caras de una misma moneda. Los modelos que apoyamos como consumidoras respaldan los diversos modelos de trabajo. Interesantes reflexiones sobre herramientas comunicativas. ¿Qué piensa #Comun_ESS? elsaltodiario.com/tecnologia/eka…
Material interesante y muy útil si te dedicas a la #comunicación dentro de la #economíasolidaria: presentaciones y relatorías el III Encuentro de Comunicación y Economía Solidaria #comun_ESS (Barcelona, marzo 2019) vía @Reas_Red economiasolidaria.org/biblioteca/mat…

Escola d'Estiu @XES_cat #CapitalismeDigital en la comunicació @cien_margaritas farà sessió: Sobredimensionem la comunicació seguint els mandats capitalistes? Quines eines usem? Ho podem fer diferent? Reptes i Propostes #Comun_ESS es podrien tenir en compte teixidora.net/wiki/COMUNESS19
"La endogamia comunicativa es el estado natural de la comunicación. Comunicamos simpre para la misma gente?" "Es mejor hablar de comu que de mk porque es mucho más rica y se sale del concepto mercado y compraventa" Més reptes de #Comun_ESS a teixidora.net/wiki/COMUN_ESS…
Reptes apuntats a #Comun_ESS per seguir discutint: "Necesitamos comunicación social, así como hay economia social" "La gente q está en las redes sociales libres está cercana a la ESS. Misma lucha" "Quizás tendríamos q empezar a usar redes libres y anunciarlo en las privativas"
I també pot alimentar aquest debat tot el que es va debatre a #Comun_ESS organitzat per la @XES_cat + @Reas_Red on es van prendre apunts de totes les sessions que podreu trobar a Teixidora.net ( @SeguimFils ) teixidora.net/wiki/COMUNESS19
I del treball conjunt va sorgir la idea d'arribar a tothom des de l'humor. Us sona? @dolorboatella @reasred #Comun_ESS
🤔 Saps com es construeix el cartell d'un esdeveniment com la #FESC2019? Amb les aportacions de totes les comissions que participen a la seva organització: logística, continguts, coordinació, gestió de persones... L'@Apostrof_coop t'ho explica aquí ➡️ fesc.xes.cat/2019/05/27/car…
Interesante iniciativa de @PandoraMirab, entidad de @ReasMadrid, para mejorar la comunicación de la #EconomiaSolidaria. Que os parece, #Comun_ESS? pandoramirabilia.net/proyectos/un-p…
🔴 Recordeu que ja tenim disponibles les presentacions i relatories del #Comun_ESS, el congrés de #comunicació i #ESS. Podeu consultar les idees, materials, debats i converses compartides amb només un clic! xes.cat/2019/04/16/ja-…

🖥️💥 Correcta intervención del VAR en el Atlético de Madrid - Barcelona. 👉🏻 Eric traba a Sorloth cuando el delantero se quedaba mano a mano con Joan García. ✅ 𝗘𝗦 𝗥𝗢𝗝𝗔 𝗗𝗜𝗥𝗘𝗖𝗧𝗔. ▪️ Koundé está suficientemente alejado para considerarse ocasión manifiesta de gol.




Material interesante y muy útil si te dedicas a la #comunicación dentro de la #economíasolidaria: presentaciones y relatorías el III Encuentro de Comunicación y Economía Solidaria #comun_ESS (Barcelona, marzo 2019) vía @Reas_Red economiasolidaria.org/biblioteca/mat…

⁉️💥 ¿Da para penalti la acción entre Koke y Dani Olmo? ✅ 𝗡𝗢. 👉🏻 Koke pone el brazo en el pecho de Dani Olmo de forma muy ligera y el delantero, tras sentir el contacto, se deja caer. ▪️ De nuevo, acción bien peritada por Clément Turpin, con la confirmación del VAR.




Felipe G. GIL @abrelatas nos sigue llevando por el camino del humor para petarlo por estas ondas y aprender también de experiencias desastrosas. Y lo estamos gozando, ritmo de remezcla, en #Comun_ESS

🚨 NOTICIA EN EXCLUSIVA Nos confirman que LAS LISTAS DEL MIR SALDRÁN HOY y que el proceso comenzará el 4 de mayo. Pendientes de confirmación oficial. #MIR26 #Medicina #residentes

Avui assistim al III Congrés de comunicació d’economia social i solidària #Comun_ESS organitzat per @XES_cat i @Reas_Red Anem a inspirar-nos per ajudar a comunicar millor.

foolish doing his best to keep up with what everyones saying in spanish and his chat helping <3

La Fundació @rocagales ja ha publicat #CooperacióCatalana 429 on hi apareixen➡️@assCandela @CarmeCherranz @FSMET_2020 #comun_ESS @CooperativesCAT @LaCoordiCat @carlaliebana @nusosSCCL @COS_Cooperativa @EspaiContraband @FoodCoopBCN @CegecopVNG 🖱 ow.ly/KGjv30o6wnQ

Laia Tresserra, compa de @opcions, nos habla de #ConsumoConsciente y estrategias para fomentarlo en el carrusel de buenas prácticas de #Comun_ESS

Eskişehirspor " La Familia Es Todo" konsept forma. La familia es una excepción. Los "Soldados del ESES" controlan el ambiente en las gradas. @Eskisehirspor 🖤❤️⚡️



Something went wrong.
Something went wrong.
United States Trends
- 1. $LOL N/A
- 2. Deni N/A
- 3. Good Wednesday N/A
- 4. Suns N/A
- 5. Hump Day N/A
- 6. Devin Booker N/A
- 7. Blazers N/A
- 8. Jalen Green N/A
- 9. $BULL N/A
- 10. Portland N/A
- 11. Erika N/A
- 12. Dillon Brooks N/A
- 13. Coby White N/A
- 14. #Our_7_Are_One_In_A_Billion N/A
- 15. Hornets N/A
- 16. Lamelo N/A
- 17. #BELIFT_Face_Boycott N/A
- 18. #RipCity N/A
- 19. Nolan McLean N/A
- 20. #DaredevilBornAgain N/A